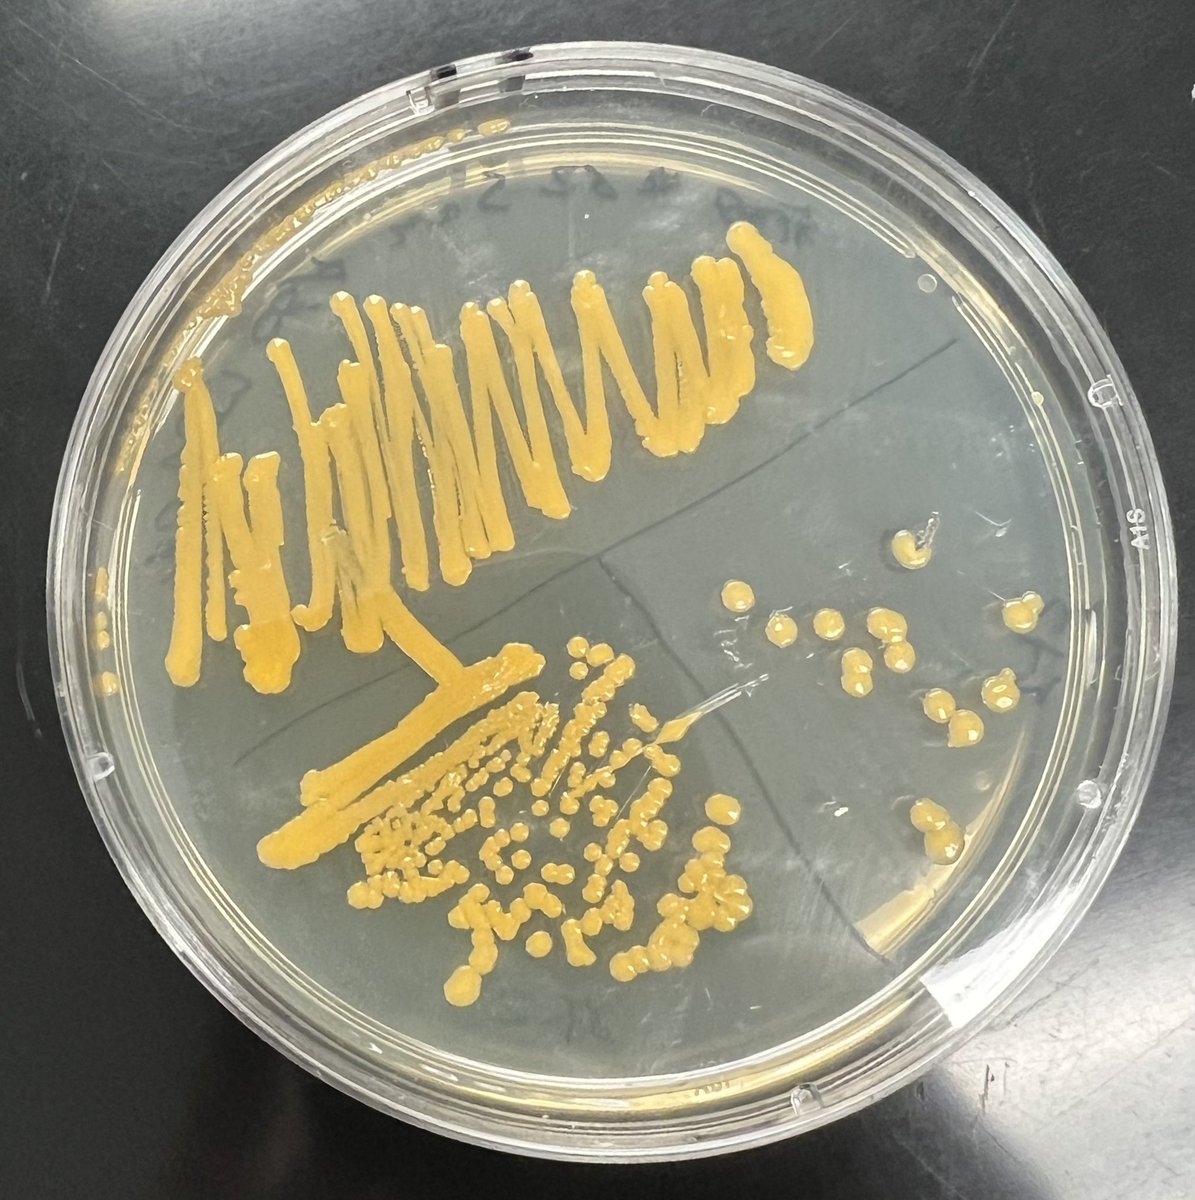
Pitt Bio Outreach tweet media

Get Your PhD @PittBioSci retweetledi
Get Your PhD @PittBioSci
229 posts


Get Your PhD @PittBioSci
@PittBioSci
Department of Biological Sciences, Dietrich School of Arts and Sciences
University of Pittsburgh Katılım Mart 2017
72 Takip Edilen609 Takipçiler
Get Your PhD @PittBioSci retweetledi

Congratulations to Tera Levin, assistant professor at @PittBioSci, for being named a 2024 PATH Investigator by @BWFund! 🎉 She'll receive $500K over 5 years to advance her research on the evolution of infectious diseases and host-pathogen interactions. pitt.ly/4aMnNuC

English
Get Your PhD @PittBioSci retweetledi

Now a junior in the Swanson School of Engineering, former Gene Team student, Oday Abushaban, credits his pre-college STEM experience with his post-secondary STEM success now. ow.ly/vyiG50RZkNm
@PittTweet
@PittEngineering
@pittbiooutreach
#STEM #Engineering #CollegeAccess
English
Get Your PhD @PittBioSci retweetledi

🚨Big news: Gene Team has earned a first-of-its kind accreditation through @MSAaccredited, elevating the value of out-of-school experiences in student success! @STEMPushNetwork @PittDietrich @PittTweet
English
Get Your PhD @PittBioSci retweetledi

The Gene Team had a very busy day of experiments! They are working on a project from the @RZ_Lab to identify bacteria from frog slime and test if it can inhibit fungal growth. They’ve already made great progress and we can’t wait to see all of their data and conclusions!

English

There are 8 hours left to give! Donations will support initiatives such as undergrad research, travel for underrepresented undergrads to national meetings, and K-12 outreach efforts
Get Your PhD @PittBioSci@PittBioSci
Today is Pitt’s Day of Giving! Consider donating to support the Department of Biological Sciences! pittdayofgiving.com/campaigns/biol…
English

Today is Pitt’s Day of Giving! Consider donating to support the Department of Biological Sciences!
pittdayofgiving.com/campaigns/biol…

English

Save the date: @PittTweet Diversity Forum is July 25-28. For more information, visit diversity.pitt.edu/events/diversi…

English
Get Your PhD @PittBioSci retweetledi

Rainbow Alliance’s LGBTQIA+ Pride Week is March 20-26th! There’s a different event almost every single day so check out the full schedule below, especially our speaker event with actor and activist Indya Moore!
#rainbowatpitt


English
Get Your PhD @PittBioSci retweetledi

RIBBiTR, a new Pitt-hosted institute funded by a $12.5 million National Science Foundation grant, will research frogs and toads bouncing back after a catastrophic brush with disease. 🐸
Full story: bit.ly/3ELy9Ms

English

Hear Dr. Walt Carson discuss deer and invasive species are devouring Pennsylvania’s forests wesa.fm/science/2021-1…
English
Get Your PhD @PittBioSci retweetledi

Join @PittBioSci!! We are #hiring 2 assistant profs #TenureTrack in computational biology, broadly writ. Do you use data?! Apply! Particularly if you're excited about modelling or the evolutionary genomics of species interactions... :) DM me with any Qs!
cfopitt.taleo.net/careersection/…

English
Get Your PhD @PittBioSci retweetledi

pls R/T My Dept is hiring a #newPI using quantitative approaches to address fundamental questions and/or emergent phenomena in biology. Come join an outstanding highly collaborative research community in awesome Chicagoland! tinyurl.com/535pcv4h
English


Gettin started with the @PittBioSci retreat! First in a long while! First up: real time poster sessions. “Prizes are not substantial but they EXIST!”

English

We still have space in our Hot Metal Bridge Post-baccalaureate fellowship program! The deadline has been extended, and we will be reviewing applications as we receive them until July 31st. asgraduate.pitt.edu/hot-metal-brid… for more information or contact cori.zawacki@pitt.edu
English
Get Your PhD @PittBioSci retweetledi

Check out our article in @NSTA Science Scope highlighting the inquiry-driven module we created with the @RZ_Lab, Ectotherm ER: Frogs Under the Weather, connecting amphibian decline with climate change nsta.org/science-scope/…
English

The Department of Biological Sciences at the University of Pittsburgh has post-baccalaureate fellowships available for students from traditionally-underrepresented groups. Applications due 4/2/2021. diversity.as.pitt.edu/hot-metal-brid…
English




